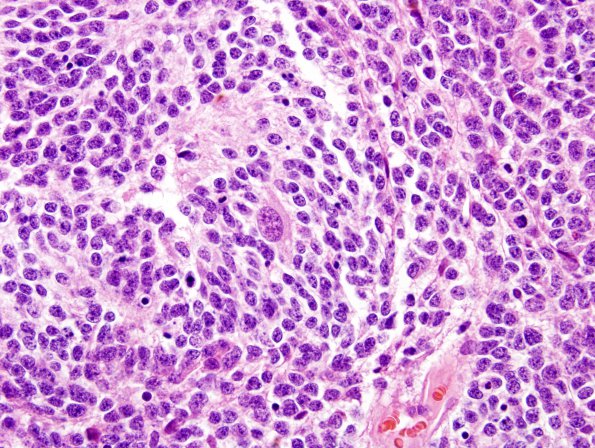
8B6 Medulloblastoma, desmoplastic (Case 8) H&E 8 (neurons)

Table of Contents
Washington University Experience | NEOPLASMS (EMBRYONAL) | Medulloblastoma, Histologically Defined | Extensive Nodularity (MBEN) | 8B6 Medulloblastoma, desmoplastic (Case 8) H&E 8 (neurons)
Among the sheets of monomorphic cells are islands of tumor cells with increased cytoplasm compared to the surrounding tumor and a lesser degree of mitotic activity. Within the pale islands are cells with a neurocytic look and occasional ganglion-like cells. (H&E)